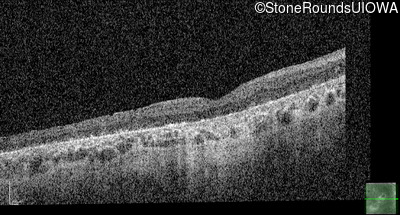
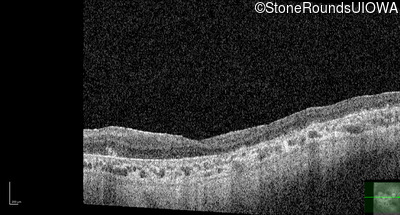

Case
SR2059
Student Mode
Bardet Biedl Syndrome (IB2)
Female
Female
Hidden
SR2059
Student Mode
Bardet Biedl Syndrome (IB2)
Female
Female
History
This 30 year old woman first experienced a reduction of visual acuity at age 20. She had no difficulties in dim light at that time. Over the next 10 years her central vision continued to worsen and she developed some difficulty seeing in dim light.
| Age at visit: 30 years |
Diagnosis & molecular findings
| Disease | Gene | Allele 1 variant(s) | Allele 2 variant(s) | Inheritance mode |
|---|---|---|---|---|
| Bardet Biedl Syndrome | BBS1 | Met390Arg ATG>AGG | Met390Arg ATG>AGG | AR |
Disease:
Gene:
Allele 1:
Met390Arg ATG>AGG
Allele 2:
Met390Arg ATG>AGG
Inheritance:
AR